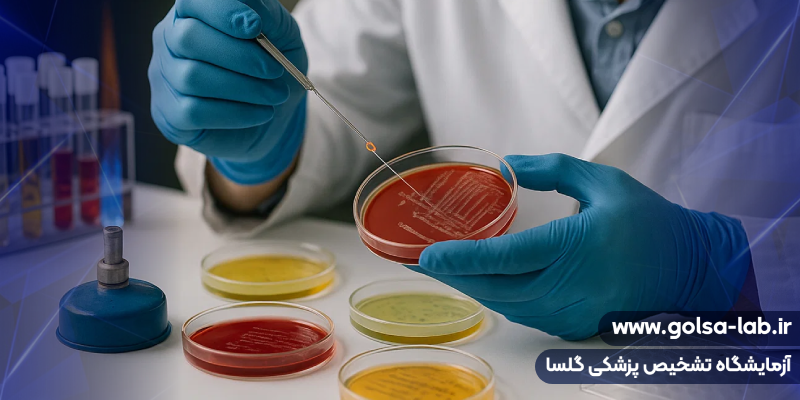
تستهای میکروب شناسی
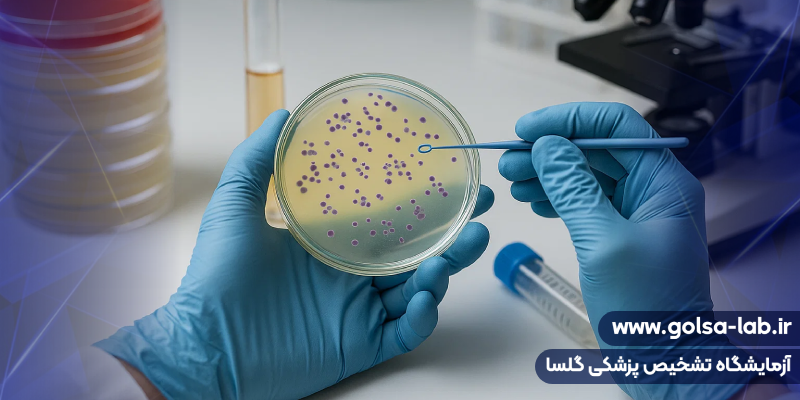
انجام تستهای میکروبی

میکروب شناسی (Microbiology) یکی از شاخههای مهم علوم زیستی است که در آزمایشگاه گلسا با دقت و تخصص بالا انجام میشود. این علم به بررسی میکروارگانیسمهایی مانند باکتریها، ویروسها، قارچها و انگلها میپردازد و نقش کلیدی در تشخیص بیماریهای عفونی، کنترل بهداشت و توسعه واکسنها و آنتیبیوتیکها دارد.
در بخش میکروبشناسی آزمایشگاه گلسا، با استفاده از تکنیکهای نوین کشت، شناسایی و آنالیز مولکولی، بررسی دقیق میکروارگانیسمها انجام میشود تا بهترین نتایج برای بیماران و مراکز درمانی فراهم گردد.
هدف از انجام آزمایشهای میکروب شناسی
هدف اصلی از انجام آزمایشهای میکروبی در آزمایشگاه گلسا، شناسایی و بررسی انواع میکروارگانیسمها و نقش آنها در سلامت انسان است. با توجه به تنوع زیاد میکروبها در طبیعت، مطالعه دقیق ساختار و عملکرد آنها به پزشکان کمک میکند تا بیماریها را سریعتر تشخیص داده و درمان مؤثرتری ارائه دهند. علاوه بر جنبه پزشکی، علم میکروبشناسی در حوزههای محیط زیست، صنایع غذایی و بیوتکنولوژی نیز کاربرد گستردهای دارد.
ابزارها و تکنیکهای تخصصی در میکروب شناسی آزمایشگاه گلسا
در آزمایشگاه گلسا از تجهیزات پیشرفته برای انجام دقیقترین تستهای میکروبی استفاده میشود. ابزارهایی مانند میکروسکوپ نوری و الکترونی، دستگاه PCR، انکوباتورهای مخصوص کشت باکتری و محیطهای انتخابی رشد، نقش مهمی در تحلیل و شناسایی میکروارگانیسمها دارند.

تکنیکهای مورد استفاده شامل موارد زیر است:
- جداسازی و شناسایی میکروارگانیسمها
در این مرحله، میکروبها از نمونههای بالینی یا محیطی جدا شده و روی محیطهای اختصاصی مانند آگار یا سابورو کشت داده میشوند. سپس با بررسی ویژگیهای ظاهری، بیوشیمیایی و مولکولی، نوع دقیق میکروارگانیسم شناسایی میگردد.
- رشد و تکثیر میکروارگانیسمها
برای رشد باکتریها و قارچها از محیطهای کشت جامد و مایع مانند تریپتون سویا، مانیتول نمکی و محیط سابورو استفاده میشود. هر محیط شرایط ویژهای برای رشد گروه خاصی از میکروبها فراهم میکند.
- شمارش باکتریها
شمارش باکتریها یکی از مراحل کلیدی در میکروب شناسی است که بهصورت مستقیم یا غیرمستقیم انجام میشود. در روش مستقیم، کلونیهای رشد یافته بر روی محیط کشت شمارش میشوند (CFU/ml)، و در روشهای غیرمستقیم از ابزارهایی مانند سیستمهای نوری، توربیدیمتری و آزمون نیترات ردوکتاز استفاده میشود.

انواع محیطهای کشت در میکروب شناسی
در بخش میکروبشناسی آزمایشگاه گلسا، بسته به نوع میکروارگانیسم، از محیطهای کشت مختلف استفاده میشود:
محیطهای جامد
- محیط آگار: برای رشد و جداسازی انواع باکتریها
- محیط سابورو: برای شناسایی و رشد قارچها
محیطهای مایع
- محیط تریپتون سویا: محیطی چندمنظوره برای رشد باکتری و قارچ
- محیط نمکی: برای رشد باکتریهای مقاوم به نمک
- محیط مالت: برای رشد میکروارگانیسمهای خاص و تجزیه مواد قندی
محیطهای انتخابی
- محیط مانیتول نمکی: برای شناسایی باکتریهای قادر به متابولیسم مانیتول
- محیط مککانکی: برای جداسازی باکتریهای گرم منفی مانند اشرشیا کلی
انواع میکروبها و ویژگیهای آنها
میکروبها یا میکروارگانیسمها، موجودات زنده بسیار کوچکی هستند که فقط با میکروسکوپ قابل مشاهدهاند. این موجودات در تمام بخشهای طبیعت از جمله آب، خاک، هوا و حتی بدن انسان وجود دارند. در میکروب شناسی آزمایشگاه گلسا، این موجودات بر اساس ساختار و عملکردشان به چند گروه اصلی تقسیم میشوند:
- باکتریها (Bacteria)
باکتریها از پرجمعیتترین و مهمترین گروههای میکروبی هستند. این موجودات تکسلولی، ساختار سادهای دارند اما نقش حیاتی در چرخه زیستی ایفا میکنند. برخی از باکتریها مفید بوده و در گوارش یا تولید ویتامین نقش دارند، در حالی که برخی دیگر میتوانند باعث بیماریهای عفونی شوند.
در آزمایشگاه گلسا، با استفاده از کشت باکتری و بررسیهای بیوشیمیایی، نوع دقیق باکتریها شناسایی میشود.
- ویروسها (Viruses)
ویروسها ذرات زندهای نیستند، بلکه ساختارهایی از DNA یا RNA هستند که تنها درون سلول میزبان میتوانند تکثیر شوند. ویروسها عامل بسیاری از بیماریها از جمله آنفلوآنزا، کرونا، هپاتیت و ایدز هستند.
در بخش ویروسشناسی آزمایشگاه گلسا، از تکنیکهای مولکولی مانند PCR برای تشخیص دقیق ویروسها استفاده میشود.
- قارچها (Fungi)
قارچها شامل کپکها، مخمرها و قارچهای بیماریزا هستند. این موجودات معمولاً در محیطهای مرطوب رشد میکنند و میتوانند در پوست، ناخن یا دستگاه تنفسی ایجاد عفونت کنند.
برای شناسایی قارچها، از محیطهای اختصاصی مانند سابورو دکستروز آگار در آزمایشگاه گلسا استفاده میشود.
- انگلها (Parasites)
انگلها موجوداتی هستند که برای زنده ماندن به بدن میزبان نیاز دارند و از منابع غذایی آن تغذیه میکنند. انگلها ممکن است در دستگاه گوارش، خون یا بافتهای بدن انسان زندگی کنند. نمونههایی مانند ژیاردیا، آمیب، مالاریا و کرمهای انگلی در این گروه قرار دارند.
در آزمایشگاه گلسا، بررسی انگلها با روشهای میکروسکوپی و تستهای سرولوژیک انجام میشود.
- جلبکها و سیانوباکترها (Algae & Cyanobacteria)
جلبکها و سیانوباکترها میکروارگانیسمهای نورگرا هستند که از نور خورشید برای تولید انرژی استفاده میکنند. برخی از آنها در محیطهای آبی نقش اکولوژیک مهمی دارند. هرچند بیشتر جلبکها بیماریزا نیستند، اما برخی گونهها میتوانند سموم زیستی خطرناک تولید کنند.
تستهای انجامشده در بخش میکروبشناسی آزمایشگاه گلسا
بخش میکروبشناسی (Microbiology Department) آزمایشگاه گلسا با بهرهگیری از تجهیزات پیشرفته و متخصصان مجرب، مجموعهای کامل از آزمایشهای میکروبی و کشتهای تخصصی را انجام میدهد.
هدف از انجام این تستها، شناسایی عوامل عفونی، بررسی حضور باکتریها، قارچها و انگلها در نمونههای بالینی و کمک به تشخیص دقیق بیماریهاست.
در ادامه، فهرست مهمترین تستهای میکروب شناسی در آزمایشگاه گلسا را مشاهده میکنید:
کشتهای میکروبی و ترشحات بدن
Urine Culture (First & Mid Stream): کشت ادرار جهت تشخیص عفونتهای ادراری (UTI)
Stool Culture: بررسی باکتریها و انگلهای دستگاه گوارش
Sputum Culture – Throat Culture: تشخیص عفونتهای ریوی و گلو
Nasal Culture: شناسایی میکروبهای عامل عفونت در ناحیه بینی
Urethral Discharge Culture: بررسی ترشحات مجرای ادرار برای تشخیص عفونتهای مقاربتی
Vaginal Discharge Culture: شناسایی عوامل عفونت واژن و بررسی تعادل فلور میکروبی
Ear Discharge Culture: بررسی عفونتهای گوش میانی و خارجی
Eye Discharge Culture: تشخیص عوامل باکتریایی یا قارچی در عفونتهای چشمی
Wound Discharge Culture: شناسایی میکروبهای موجود در زخمهای عفونی
Nipple Discharge Culture: بررسی ترشحات پستان برای تشخیص عفونتهای موضعی یا باکتریایی
کشت خون و سایر مایعات بدن
Blood Culture & Other Body Fluid Culture: کشت خون و مایعات بدن جهت تشخیص عفونتهای سیستمیک و سپسیس
تستهای تخصصی انگلی و تشخیصی
Occult Blood – Scotch Tape Test: تست خون مخفی در مدفوع و تست انگلهای رودهای
Leishmania – Scabies: بررسی وجود انگلهای پوستی مانند سالک (لیشمانیا) و جرب (اسکبی)
آزمایش ادرار و بررسیهای عمومی
Urinalysis With Urine Strip Reader: آزمایش کامل ادرار شامل بررسی فیزیکی، شیمیایی و میکروسکوپی با استفاده از دستگاه خوانش نوار ادراری
اهمیت انجام تستهای میکروبی در آزمایشگاه گلسا
انجام بهموقع و دقیق تستهای میکروب شناسی نقش حیاتی در تشخیص زودهنگام بیماریهای عفونی دارد. در آزمایشگاه گلسا تمام مراحل از نمونهگیری تا کشت و شناسایی نهایی میکروارگانیسمها با رعایت کامل اصول کنترل کیفی انجام میشود تا نتایج دقیق، قابل اعتماد و مطابق با استانداردهای بینالمللی ارائه گردد.
اهمیت میکروب شناسی در تشخیص و درمان بیماریها
علم میکروبشناسی بالینی پایه و اساس تشخیص بسیاری از بیماریهای عفونی است. در آزمایشگاه گلسا، نمونههای مختلف مانند خون، ادرار، ترشحات گلو، زخم و مدفوع مورد بررسی قرار میگیرند تا عامل عفونت شناسایی شود. این اطلاعات به پزشکان کمک میکند تا بهترین نوع درمان آنتیبیوتیکی را انتخاب کرده و از مصرف بیرویه داروها جلوگیری شود.
نتیجهگیری
میکروب شناسی در آزمایشگاه گلسا ترکیبی از علم، دقت و فناوری است. با بهرهگیری از تجهیزات پیشرفته و کارشناسان متخصص، این بخش نقش مؤثری در تشخیص دقیق بیماریهای عفونی، پیشگیری از اپیدمیها و ارتقای بهداشت عمومی ایفا میکند.
مطالعه میکروارگانیسمها نهتنها به درک بهتر دنیای میکروسکوپی کمک میکند، بلکه راه را برای توسعه درمانهای نوین و واکسنهای مؤثر نیز هموار میسازد.



